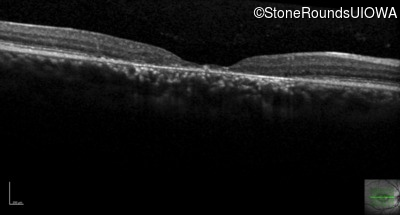
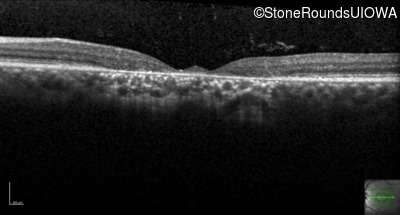
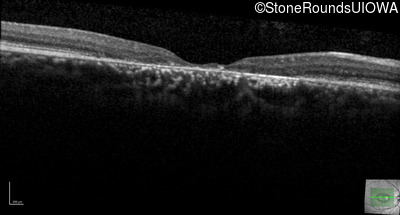
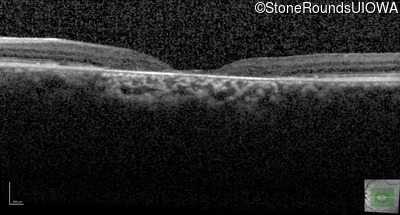
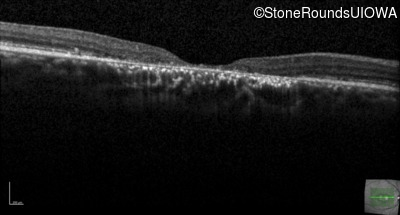
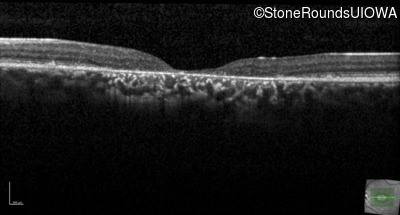

Case
SR381
Student Mode
AR Stargardt Disease (IIA)
Male
Male
Hidden
SR381
Student Mode
AR Stargardt Disease (IIA)
Male
Male
History
This 29-year-old man had good vision until his early 20's. at which time he began to experience a slow reduction in his acuity. His driver's license was restricted at age 27.
| Age at visit: 29 years |
| Age at visit: 30 years |
| Age at visit: 31 years |
Diagnosis & molecular findings
| Disease | Gene | Allele 1 variant(s) | Allele 2 variant(s) | Inheritance mode |
|---|---|---|---|---|
| AR Stargardt Disease | ABCA4 | Gln1513Arg CAG>CGG | Arg2107His CGC>CAC | AR |
Disease:
Gene:
Allele 1:
Gln1513Arg CAG>CGG
Allele 2:
Arg2107His CGC>CAC
Inheritance:
AR